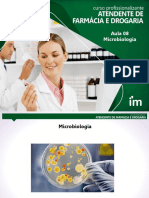

0% acharam este documento útil (0 voto)
361 visualizações43 páginasAula 01 - INTRODUÇÃO AOS FUNGOS PDF
O documento apresenta uma introdução à micologia, abordando: 1) Características gerais dos fungos, como serem heterotróficos, unicelulares ou pluricelulares, e habitarem diversos ambientes; 2) Morfologia dos fungos filamentosos e leveduriformes; 3) Ciclo de vida dos fungos, incluindo reprodução assexuada e sexuada.
Enviado por
Lucas Da SilvaDireitos autorais
© © All Rights Reserved
Levamos muito a sério os direitos de conteúdo. Se você suspeita que este conteúdo é seu, reivindique-o aqui.
Formatos disponíveis
Baixe no formato PDF, TXT ou leia on-line no Scribd
0% acharam este documento útil (0 voto)
361 visualizações43 páginasAula 01 - INTRODUÇÃO AOS FUNGOS PDF
O documento apresenta uma introdução à micologia, abordando: 1) Características gerais dos fungos, como serem heterotróficos, unicelulares ou pluricelulares, e habitarem diversos ambientes; 2) Morfologia dos fungos filamentosos e leveduriformes; 3) Ciclo de vida dos fungos, incluindo reprodução assexuada e sexuada.
Enviado por
Lucas Da SilvaDireitos autorais
© © All Rights Reserved
Levamos muito a sério os direitos de conteúdo. Se você suspeita que este conteúdo é seu, reivindique-o aqui.
Formatos disponíveis
Baixe no formato PDF, TXT ou leia on-line no Scribd